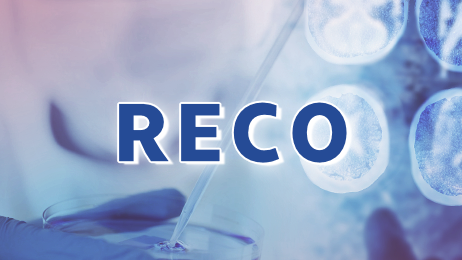

【扫一扫】
关注更多中心的最新动态

BAST
北京天坛医院
主要研究者:缪中荣 教授 王伊龙 教授
在研

ANGEL
北京天坛医院
主要研究者:缪中荣 教授
筹备中

RESCUE-REESE
北京天坛医院
主要研究者:刘丽萍 教授
测试中

BASTFOLLOW
首都医科大学附属北京天坛医院
主要研究者:缪中荣 教授 王伊龙 教授
筹备中

ANGEL-ACT II
北京天坛医院
主要研究者:缪中荣 教授
筹备中

ANGEL-ACT (RECO)
北京天坛医院
主要研究者:教授
筹备中

EPOCH
首都医科大学附属北京天坛医院
主要研究者:缪中荣 教授
筹备中

SHINE
首都医科大学附属北京天坛医院
主要研究者:王拥军 教授
筹备中
TRUST
郑州大学第一附属医院
主要研究者:宋波 教授
在研

【或者长按维码进行关注】
(了解更多项目 实时关注项目进度等)

北京指南科技有限公司
联系电话:400-067-068
工作时间:工作日9:00-18:00